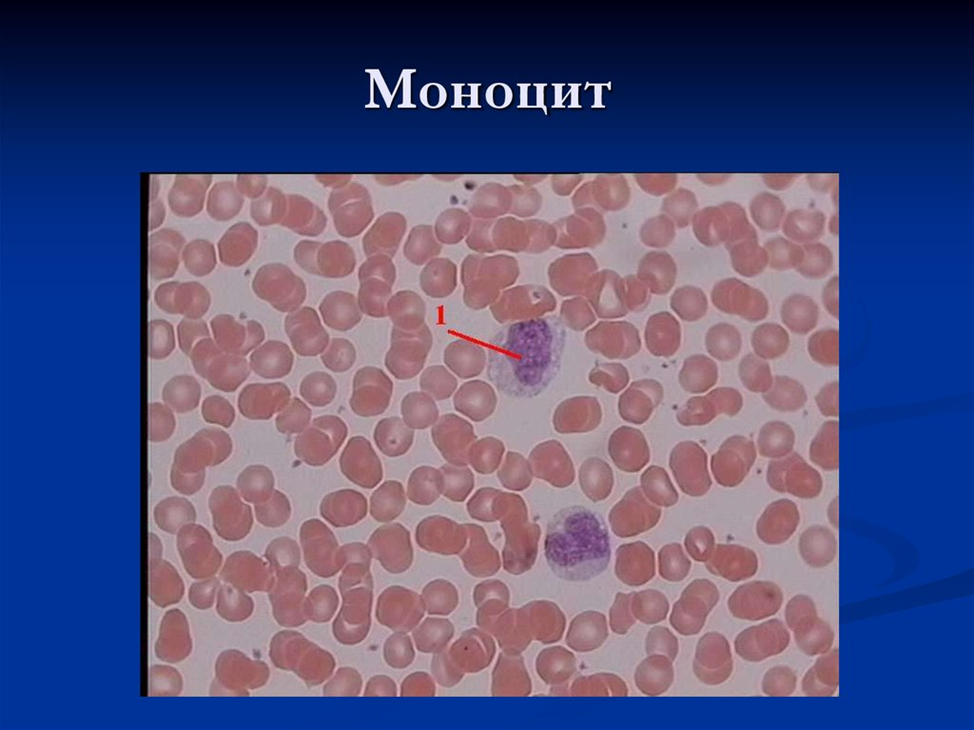

СР Особенности метаболизма лейкоцитов
Виды лейкоцитов
Нейтрофилы
Нейтрофи́лы, или нейтрофи́льные гранулоци́ты, или нейтрофи́льные сегментоя́дерные гранулоци́ты, или полиморфонуклеа́рные нейтрофи́лы, — наиболее многочисленная группа гранулоцитов, на долю которой приходится от 40 % до 70 % всех лейкоцитов у человека. Нейтрофилы являются частью врождённого иммунитета, их основная функция — фагоцитоз патогенных микроорганизмов (бактерий, грибков, простейших) и продуктов распада тканей организма.
Нейтрофилы представляют собой очень подвижные клетки, которые проникают даже в те ткани, которые недоступны для других лейкоцитов. В зависимости от морфологии ядра нейтрофилы подразделяют на палочкоядерные (незрелые) и сегментоядерные (зрелые) нейтрофилы. Развитие нейтрофилов находится под контролем цитокинов, прежде всего G-CSF, а также GM-CSF, IL-3 и IL-6. В условиях воспалительного ответа количество нейтрофилов увеличивается под действием IL-17и IL-23.
Нейтрофилы являются основными фагоцитами кровотока, но в ходе острого воспаления интенсивно мигрируют в очаг воспаления. Они проникают через стенки кровеносных сосудов и движутся по градиенту различных провоспалительных молекул в ходе хемотаксиса. Нейтрофилы — самые многочисленные клетки, входящие в состав гноя, именно они придают ему беловатый или желтоватый цвет.


Нетоз - программированная клеточная гибель нейтрофилов
Нетоз сопровождается выбросом из погибающих нейтрофилов нитей, состоящих
в основном из ДНК. Благодаря нетозу нейтрофилы убивают внеклеточные патогены,
минимизируя вред для других клеток. Считается, что нетоз запускается при
активации НАДН-оксидазы, которая начинает вырабатывать АФК. Они активируют
фермент протеин-аргининдезаминазу 4, которая вызывает цитруллирование гистонов
в ядре нейтрофила, хроматин декомпактизируется. Миелопероксидаза и эластаза
приводят к разрушению ядерной оболочки, деконденсированный хроматин выходит в
цитоплазму. Цитоплазматические белки с хроматином формируют внеклеточные нити (NETs).

Нетоз может быть суицидальный и витальный
• СУИЦИДАЛЬНЫЙ нетоз запускается активацией различных рецепторов (например, комплемента) лигандами (антителами), что приводит к выбросу ионов кальция, который активирует НАДН-оксидазу. Этот процесс сопровождается разрушением мембраны и гибелью нейтрофилов. Продолжается несколько часов.
• ВИТАЛЬНЫЙ нетоз запускается липополисахаридами и другими антигенами бактерий, активированными тромбоцитами или белками комплемента. Происходит блеббинг (отшнуровывание пузырьков) ядра, везикулы с ДНК выделяются экзоцитозом без повреждения мембраны нейтрофила. Нейтрофил не погибает, но лишается ядра и продолжает фагоцитировать клетки микроорганизмов. Продолжается секунды.

Отрицательный эффект NETs
Выход гистонов во внеклеточную среду может запустить развитие аутоиммунных заболеваний(системная красная волчанка), развитие воспалительных (преэкламсия, колит) и онкологических заболеваний. NETs также могут участвовать в тромбозе, сердечных приступах, метастазировании, в смертельных случаях заболеваний, вызванных ковид-19. Таким образом, имеется ряд свидетельств того, что NETs играют важную роль в патогенезе инфекционных, воспалительных и тромбических заболеваний.
Эозинофилы
Разновидность лейкоцитов, основная функция которых заключается в борьбе с многоклеточными паразитами. Зрелые эозинофилы имеют ядро, разделённое на две части, и эозинофильные гранулы, содержащие белки с цитотоксическими свойствами. Молекулярными маркерами эозинофилов являются белки CD9 и CD35. У здорового человека эозинофилы составляют от 0,5% до 2% от общего числа лейкоцитов

Базофилы
• являются разновидностью лейкоцитов, которые участвуют в развитии аллергических реакций. Своё название базофилы получили из-за наличия в цитоплазме базофильных гранул. У человека доля базофилов от числа лейкоцитов в крови составляет 0,5 %. Диаметр базофилов в мазке крови составляет 11—12 мкм, в капле крови — 9 мкм. Морфологически базофилы близки не только к другим гранулоцитам, но и к тучным клеткам, с которыми они тесно связаны функционально.
• Базофильные гранулы, находящиеся в цитоплазме базофилов, содержат гистамин, протеазы химазу и триптазу, некоторые другие ферменты, протеогликаны (преимущественно хондроитинсульфаты) и гликозаминогликаны. Базофилы секретируют сравнительно немного активных веществ: лейкотриен C3, интерлейкины IL-4 и IL-13[en] и некоторые другие цитокины.
• Вместе с эозинофилами и нейтрофилами они мигрируют в очаг аллергического воспаления из кровотока. Связывание иммуноглобулинов E с Fc-рецепторами на базофилах активирует их, и базофилы начинают выделять наружу содержимое гранул. Высвобождение содержимого гранул базофилов обеспечивает поддержание аллергического процесса, инициированного тучными клетками

Моноциты
Крупные лейкоциты системы мононуклеарных макрофагов, их диаметр в мазке крови достигает 18-20 мкм. После выхода в кровь моноциты циркулируют в кровотоке 1-2 дня, после чего оседают в тканях и становятся резидентными макрофагами. Моноциты сами по себе являются клетками врождённого иммунитета и несут паттерн распознающие рецепторы и рецепторы хемокинов, благодаря которым они могут перемещаться в очаг воспаления, где секретируют провоспалительные цитокины и участвуют в фагоцитозе.
Лимфоциты
Клетки иммунной системы, представляющие собой разновидность лейкоцитов группы агранулоцитов. Лимфоциты - главные клетки иммунной системы обеспечивают гуморальный иммунитет, клеточный иммунитет, а также регулируют деятельность клеток других типов. В организме взрослого человека 25-40% всех лейкоцитов крови составляют лимфоциты, у детей доля этих клеток равна 50%.
